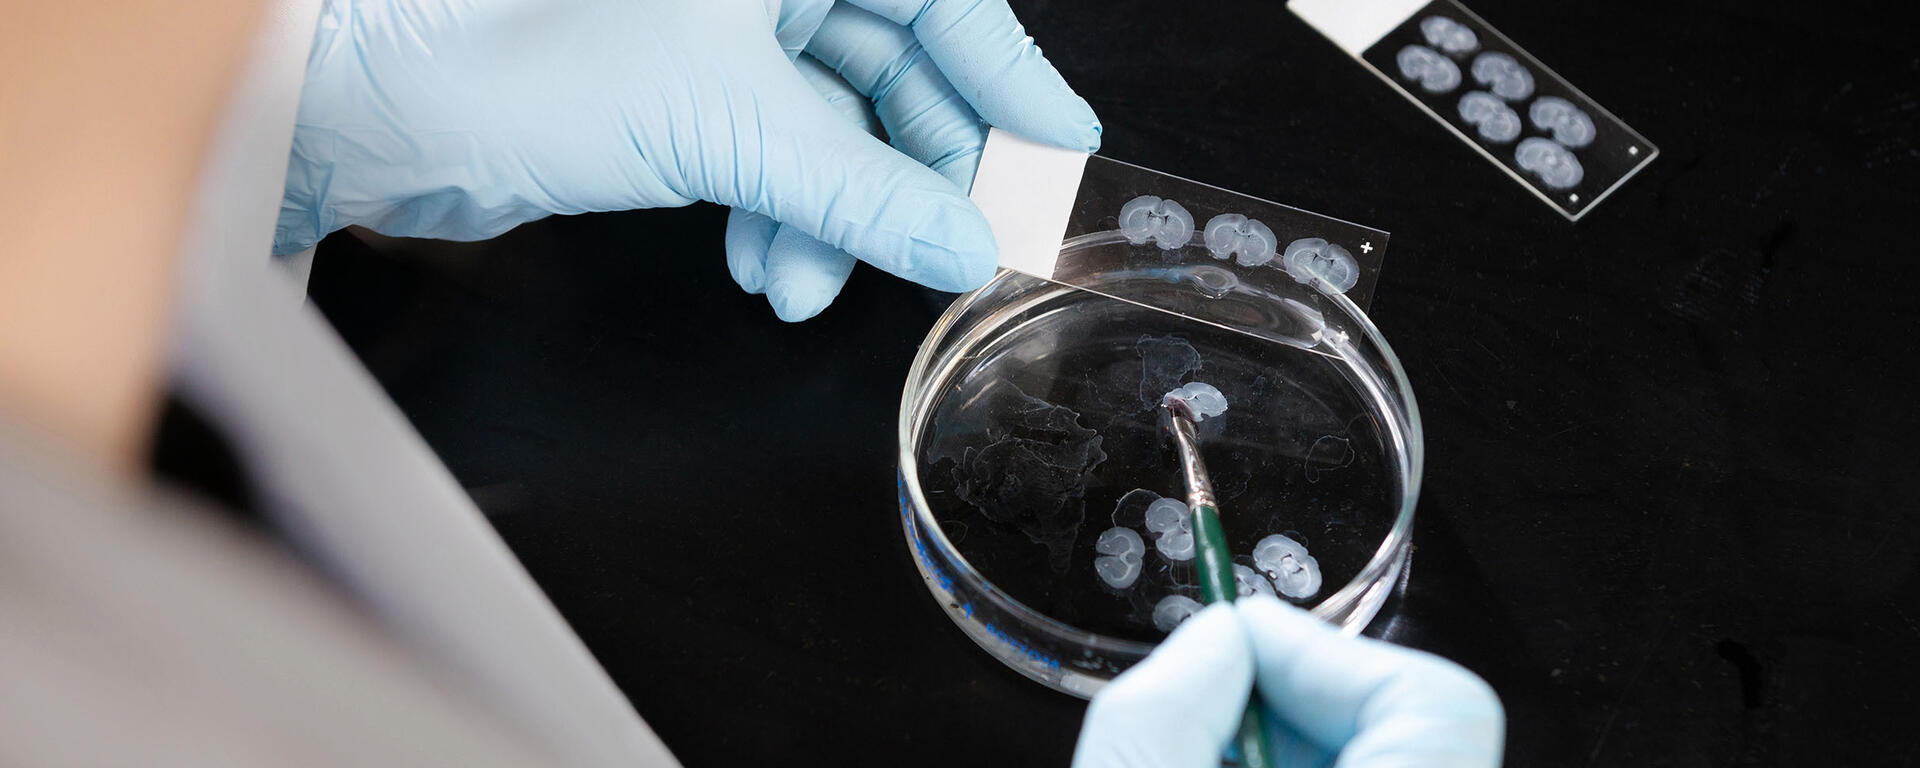
Close up of researcher transferring rodent brain slices from a Petri dish to slides.

Preclinical research is foundational research
How does foundational research work?
Research highlight
MIST Research Chair Dr. Matthew Hill conducts foundational research in the area of endocannabinoids (eCB), our body’s own endogenous cannabinoids (compounds found in cannabis).
- Research in rodents: First, examined how eCB impact emotional behaviour in rodents, and found that increasing eCB can reduce stress and anxiety.
- Discover mechanisms: Then, determined the brain region eCB work on to alleviate stress and anxiety in rodents (amygdala). Further, established that genetic or medicinal manipulations of eCB also affect brain activity in the amygdala.
- Research in humans: Next, examined whether elevated eCB could dampen biological markers of stress, fear and anxiety in humans — and found that they can.
- Clinical trial: Produced enough foundational research evidence demonstrating the importance of eCB in stress regulation that approval was given to start a clinical trial with a medication that boosts eCB to treat post-traumatic stress disorder.

The three steps involved in foundational research that inform clinical trials.
MIST will focus on two key areas of foundational research:
Stress is a major precipitating factor for mental health conditions, but how stress impacts the brain to increase this vulnerability is unclear. MIST aims to discover what brain chemical systems and brain circuits are affected by stress to increase this vulnerability. This will create science-informed approaches to investigate medicinal targets (based on brain chemical changes) and brain stimulation targets (based on brain circuit changes) to treat stress-related mental health conditions.
It is clear that traumatic brain injury (TBI) increases risk of developing mental health conditions, especially stress-related ones like major depression and post-traumatic stress disorder. However, how TBI alters the brain’s ability to process stress is limited; more so, research on whether a history of chronic (longterm) stress can influence outcomes like brain inflammation following TBI is limited. MIST is exploring these questions in both rodent models and humans who have experienced a TBI.
The bedrock for future progress
Foundational science is fundamental to our understanding of the brain's workings and its ailments. It forms the bedrock for future progress in medicine.
Dr. David Park, PhD, FRSC
Director, The Hotchkiss Brain Institute